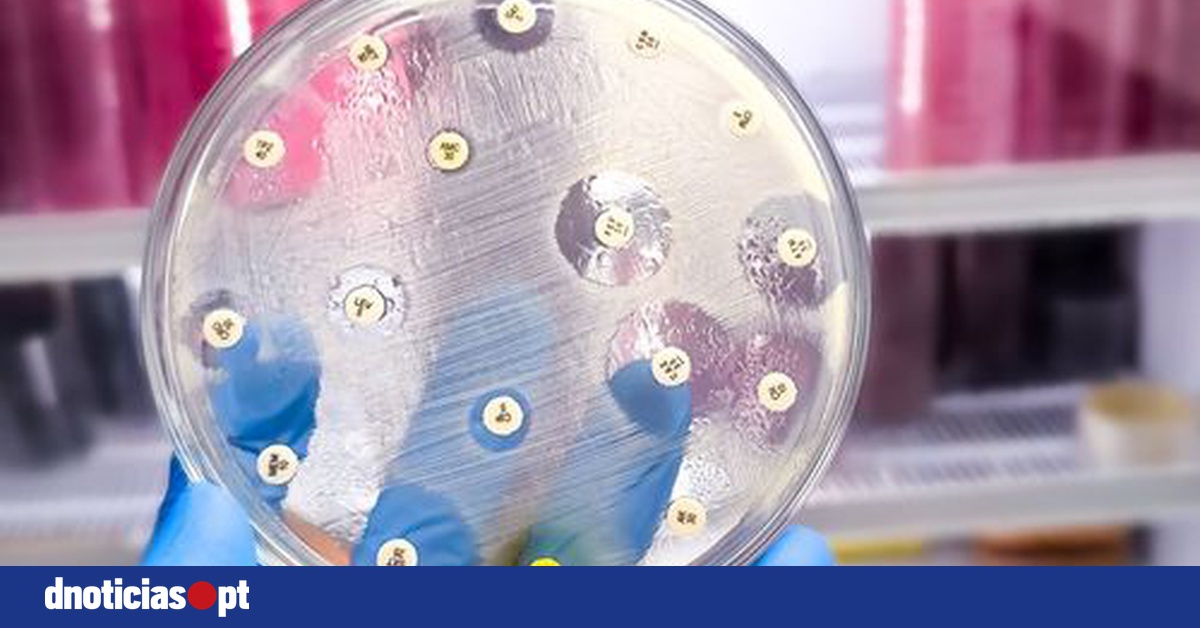
DNOTICIAS.PT

Resistência aos antibióticos aumentou 40% entre 2018 e 2023 e é ameaça crescente

A resistência aos antibióticos aumentou em mais de 40% entre 2018 e 2023, segundo a Organização Mundial de Saúde (OMS), que avisa que este crescimento representa uma ameaça crescente para a saúde global.
Uma em cada seis infeções bacterianas confirmadas em laboratório e que causaram em 2023 doenças comuns em pessoas de todo o mundo eram resistentes aos tratamentos com antibióticos, segundo um novo relatório OMS.
Segundo a organização, entre 2018 e 2023, a resistência aos antibióticos aumentou em mais de 40% dos antibióticos monitorizados, com um aumento médio anual de 5 a 15%.
Os dados reportados ao Sistema Global de Vigilância da Resistência e Uso de Antimicrobianos (GLASS, sigla em inglês) da OMS por mais de 100 países alertam para a ameaça crescente deste aumento, sendo que a organização estima que a resistência aos antibióticos seja maior nas regiões do Sudeste Asiático e do Mediterrâneo Oriental, onde uma em cada três infeções notificadas eram resistentes. Na Região Africana a resistência surge em uma em cada cinco infeções.
A resistência é também mais comum e está a agravar-se em locais onde os sistemas de saúde não têm capacidade para diagnosticar ou tratar agentes patogénicos bacterianos, avisa a OMS.
O Relatório Global de Vigilância da Resistência aos Antibióticos de 2025 apresenta, pela primeira vez, estimativas de prevalência de resistência a 22 antibióticos utilizados para tratar infeções do trato urinário e gastrointestinal, da corrente sanguínea e os utilizados para tratar a gonorreia.
O relatório abrange oito agentes patogénicos bacterianos comuns -- Acinetobacter spp., Escherichia coli (E.coli), Klebsiella pneumoniae, Neisseria gonorrhoeae, Salmonella spp. não tifóide, Shigella spp., Staphylococcus aureus e Streptococcus pneumoniae -- cada um deles associado a uma ou mais destas infeções.
"A resistência antimicrobiana está a ultrapassar os avanços da medicina moderna, ameaçando a saúde das famílias em todo o mundo", afirmou Tedros Adhanom Ghebreyesus, diretor-geral da OMS, citado na nota hoje divulgada.
O responsável considera ainda que, à medida que os países reforçam os seus sistemas de vigilância da resistência antimicrobiana, é preciso "utilizar os antibióticos de forma responsável e garantir que todos têm acesso aos medicamentos certos, aos diagnósticos com garantia de qualidade e às vacinas".
"O nosso futuro depende também do reforço dos sistemas de prevenção, diagnóstico e tratamento de infeções e da inovação com antibióticos de última geração e testes moleculares rápidos no local de prestação de cuidados", acrescentou.
O novo relatório observa que as bactérias Gram-negativas resistentes aos medicamentos estão a tornar-se mais perigosas em todo o mundo, sendo que a maior carga recai sobre os países menos equipados para responder.
Entre estas, a E. coli e a K. pneumoniae são as principais bactérias Gram-negativas resistentes encontradas nas infeções da corrente sanguínea, que estão entre as infeções bacterianas mais graves e resultam frequentemente em sépsis, falência de órgãos e morte.
No entanto, mais de 40% das E. coli e mais de 55% das K. pneumoniae em todo o mundo são agora resistentes às cefalosporinas de terceira geração, o tratamento de primeira escolha para estas infeções. Na Região Africana a resistência ultrapassa os 70%.
O relatório avisa ainda que outros antibióticos essenciais para salvar vidas, incluindo os carbapenemos e as fluoroquinolonas, estão a perder eficácia contra E. coli, K. pneumoniae, Salmonella e Acinetobacter e sublinha que a resistência aos carbapenemos, outrora rara, está a tornar-se mais frequente, restringindo as opções de tratamento e obrigando a dependência de antibióticos de último recurso, que são caros, de difícil acesso e frequentemente indisponíveis em países de baixo e médio rendimento.
A participação dos países no GLASS aumentou mais de quatro vezes (25 países em 2016 e 104 países em 2023), mas 48% não reportou dados em 2023 e cerca de metade dos países que o fizeram ainda não tinham os sistemas necessários para gerar dados fiáveis. De facto -- assinala a OMS -, os países que enfrentavam os maiores desafios não tinham capacidade de vigilância para avaliar a sua situação de resistência antimicrobiana.
Lembra que a declaração política sobre a resistência antimicrobiana adotada na Assembleia Geral das Nações Unidas em 2024 estabeleceu metas para lidar com este problema através do reforço dos sistemas de saúde e da colaboração com uma abordagem de "Uma Única Saúde" (One Health), coordenando os setores da saúde humana, saúde animal e ambiente.
A este nível, a OMS reforça que para combater o crescente desafio da resistência antimicrobiana os países devem comprometer-se a reforçar os sistemas laboratoriais e a gerar dados de vigilância fiáveis.
Apela ainda a todos os países para que reportem dados de elevada qualidade sobre esta matéria ao GLASS até 2030, sublinhando que "alcançar esta meta exigirá uma ação concertada para reforçar a qualidade, a cobertura geográfica e a partilha de dados de vigilância da resistência antimicrobiana para acompanhar o progresso".
Defende igualmente que os países devem ampliar as intervenções coordenadas destinadas a combater a resistência antimicrobiana a todos os níveis de assistência médica e garantir que as orientações de tratamento e as listas de medicamentos essenciais estão alinhadas com os padrões locais de resistência.